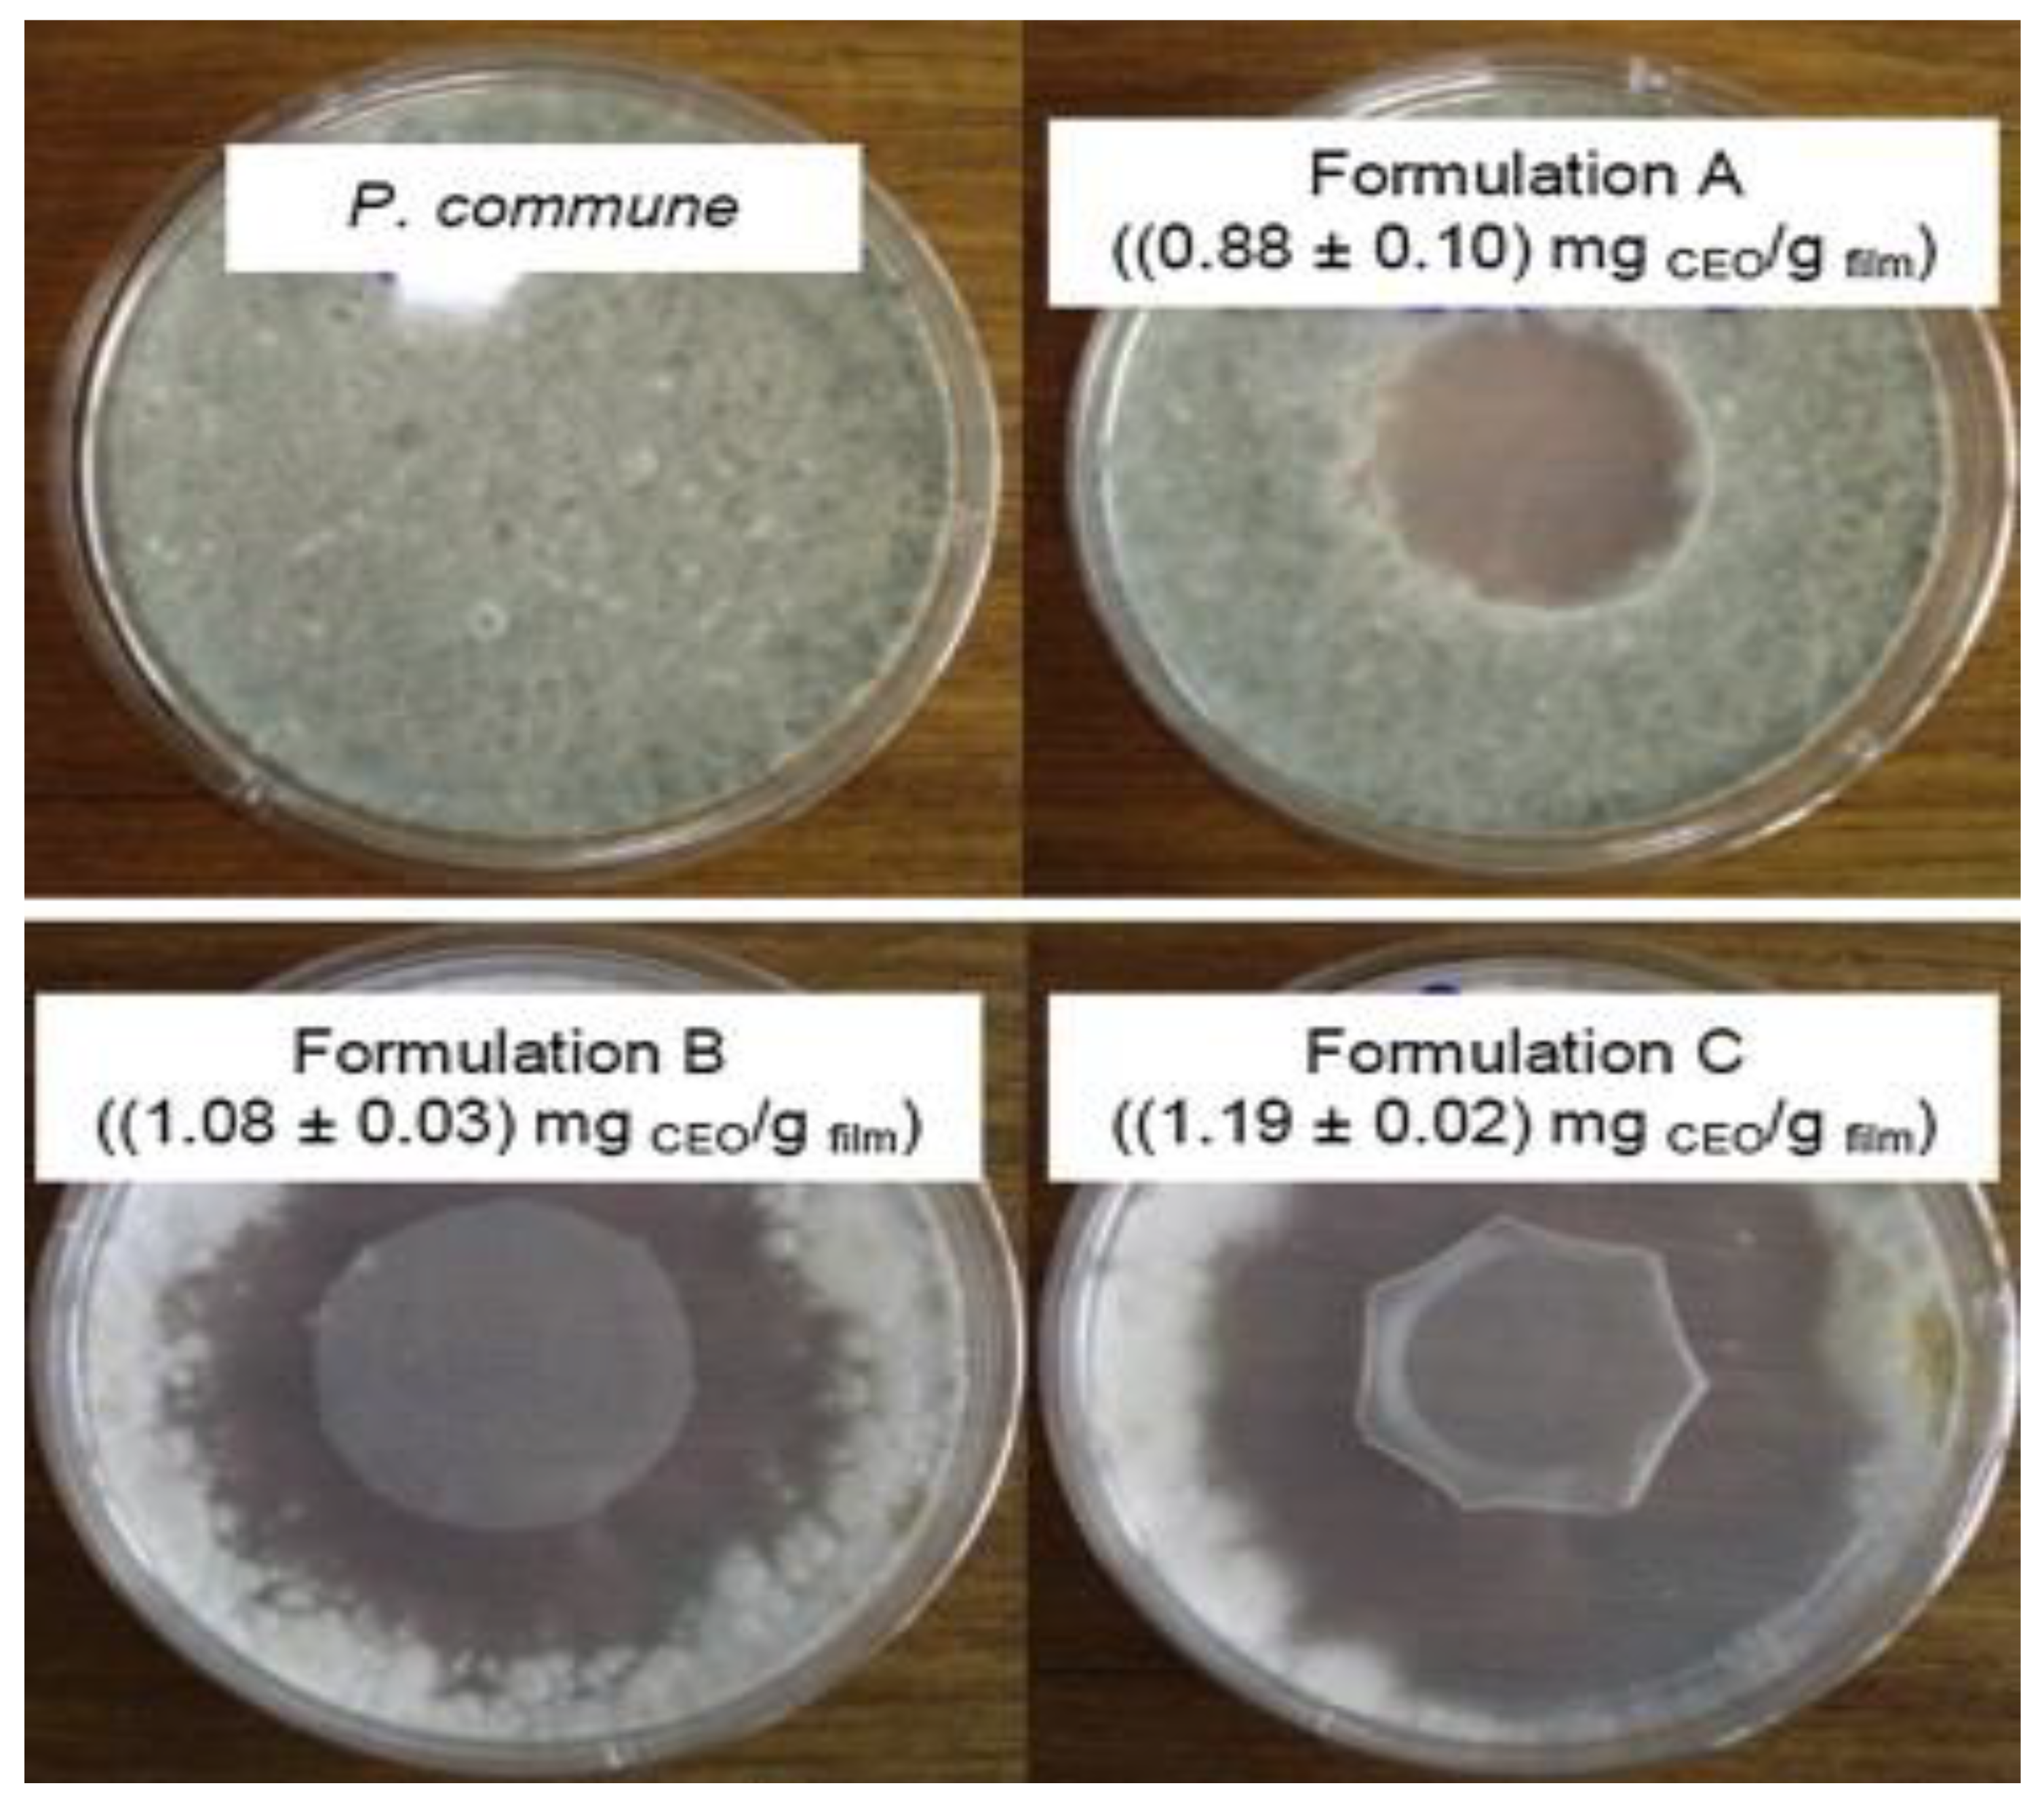

Antimicrobial Activities of Starch-Based Biopolymers and Biocomposites Incorporated with Plant Essential Oils: A Review
Abstract
1. Introduction
2. Starch-Based Polymer Film Incorporated with Antimicrobial Plant Essential Oils
2.1. Antimicrobial Properties of Starch-Based Polymer Film Incorporated with Antimicrobial Plant Essential Oils
2.2. The Mechanisms of Action of EOs in Antimicrobial Activity
- IEC 68-2-10: Clear techniques for monitoring the environment
- EN ISO 846: Plastics-appraisal of microorganisms’ action
- ASTM G21-90: Standard practice for determining synthetic polymeric fabric’s resistance to fungi
- ASTM G22-76: Standard practice for assessing immunity to bacteria in synthetic polymeric products.
- Acetic acid from vinegar
- Benzoic acid from cranberries, plums, prunes, cinnamon, cloves, and most berries
- Lactic acid from lactic acid bacteria
- Propionic acid from Swiss cheese (Propionibacterium freudenreichii ssp. Shermanii)
- Sorbic acid from rowanberries
2.3. Mechanical Properties of Anti-Microbacterial Agent Incorporated Starch Biopolymer
2.4. Water Barrier Properties of Anti-Microbacterial Agent Reinforced Starch Biopolymer
2.5. Antimicrobial Activities of Nanocellulose Reinforced Starch Bionanocomposites with EOs
3. Antimicrobial Properties of Polymer Composites Reinforced Essential Oil
4. Conclusions
Author Contributions
Funding
Conflicts of Interest
References
- Resianingrum, R. Characterization of cassava starch-based edible film enriched with lemongrass oil (Cymbopogon citratus). Nusant. Biosci. 2016, 8, 278–282. [Google Scholar] [CrossRef]
- Aisyah, H.A.; Tahir, P.M.; Sapuan, S.M.; Khalina, A.; Berkalp, O.B.; Lee, S.H.; Lee, C.H.; Nurazzi, N.M.; Ramli, N.; Wahab, M.S.; et al. Thermal properties of woven kenaf/carbon fibre-reinforced epoxy hybrid composite panels. Int. J. Polym. Sci. 2019, 2019, 5258621. [Google Scholar] [CrossRef]
- Atiqah, A.; Jawaid, M.; Jawaid, M.; Ishak, M.; Ansari, M.; Ilyas, R. Physical and thermal properties of treated sugar palm/glass fibre reinforced thermoplastic polyurethane hybrid composites. J. Mater. Res. Technol. 2019, 8, 3726–3732. [Google Scholar] [CrossRef]
- Abral, H.; Ariksa, J.; Mahardika, M.; Handayani, D.; Aminah, I.; Sandrawati, N.; Pratama, A.B.; Fajri, N.; Sapuan, S.; Ilyas, R. Transparent and antimicrobial cellulose film from ginger nanofiber. Food Hydrocoll. 2020, 98, 105266. [Google Scholar] [CrossRef]
- Abral, H.; Basri, A.; Muhammad, F.; Fernando, Y.; Hafizulhaq, F.; Mahardika, M.; Sugiarti, E.; Sapuan, S.; Ilyas, R.; Stephane, I.; et al. A simple method for improving the properties of the sago starch films prepared by using ultrasonication treatment. Food Hydrocoll. 2019, 93, 276–283. [Google Scholar] [CrossRef]
- Abral, H.; Atmajaya, A.; Mahardika, M.; Hafizulhaq, F.; Kadriadi; Handayani, D.; Sapuan, S.; Ilyas, R. Effect of ultrasonication duration of polyvinyl alcohol (PVA) gel on characterizations of PVA film. J. Mater. Res. Technol. 2020, 9, 2477–2486. [Google Scholar] [CrossRef]
- Souza, A.; Goto, G.; Mainardi, J.; Coelho, A.C.V.; Tadini, C. Cassava starch composite films incorporated with cinnamon essential oil: Antimicrobial activity, microstructure, mechanical and barrier properties. LWT Food. Sci. Technol. 2013, 54, 346–352. [Google Scholar] [CrossRef]
- Ilyas, R.A.; Sapuan, S.M.; Atiqah, A.; Ibrahim, R.; Abral, H.; Ishak, M.R.; Zainudin, E.S.; Nurazzi, N.M.; Atikah, M.S.N.; Ansari, M.N.M.; et al. Sugar palm (Arenga pinnata [Wurmb.] Merr) starch films containing sugar palm nanofibrillated cellulose as reinforcement: Water barrier properties. Polym. Compos. 2019, 41, 459–467. [Google Scholar] [CrossRef]
- Ilyas, R.; Sapuan, S.; Atikah, M.; Asyraf, M.; Rafiqah, S.A.; Aisyah, H.; Nurazzi, N.M.; Norrrahim, M. Effect of hydrolysis time on the morphological, physical, chemical, and thermal behavior of sugar palm nanocrystalline cellulose (Arenga pinnata (Wurmb.) Merr). Text. Res. J. 2020, 004051752093239. [Google Scholar] [CrossRef]
- Ilyas, R.; Sapuan, S.M.; Ishak, M.; Zainudin, E.S. Development and characterization of sugar palm nanocrystalline cellulose reinforced sugar palm starch bionanocomposites. Carbohydr. Polym. 2018, 202, 186–202. [Google Scholar] [CrossRef]
- Sanyang, M.L.; Ilyas, R.A.; Sapuan, S.M.; Jumaidin, R. Sugar palm starch-based composites for packaging applications. In Bionanocomposites for Packaging Applications; Springer International Publishing: Cham, Switzerland, 2018; pp. 125–147. ISBN 9783319673196. [Google Scholar]
- Ilyas, R.A.; Sapuan, S.M.; Ishak, M.R.; Zainudin, E.S. Sugar palm nanocrystalline cellulose reinforced sugar palm starch composite: Degradation and water-barrier properties. In IOP Conference Series: Materials Science and Engineering, Proceedings of the Wood and Biofiber International Conference (WOBIC 2017), Selangor, Malaysia, 21–23 November 2017; Hotel Putrajaya-Bangi: Selangor, Malaysia, 2018; Volume 368. [Google Scholar]
- Mazani, N.; Sapuan, S.M.; Sanyang, M.L.; Atiqah, A.; Ilyas, R.A. Design and fabrication of a shoe shelf from kenaf fiber reinforced unsaturated polyester composites. In Lignocellulose for Future Bioeconomy; Elsevier: Amsterdam, The Netherlands, 2019; pp. 315–332. ISBN 9780128163542. [Google Scholar]
- Syafri, E.; Sudirman; Mashadi; Yulianti, E.; Deswita; Asrofi, M.; Abral, H.; Sapuan, S.; Ilyas, R.; Fudholi, A. Effect of sonication time on the thermal stability, moisture absorption, and biodegradation of water hyacinth (Eichhornia crassipes) nanocellulose-filled bengkuang (Pachyrhizus erosus) starch biocomposites. J. Mater. Res. Technol. 2019, 8, 6223–6231. [Google Scholar] [CrossRef]
- Ilyas, R.; Sapuan, S. The preparation methods and processing of natural fibre bio-polymer composites. Curr. Org. Synth. 2020, 16, 1068–1070. [Google Scholar] [CrossRef]
- Ilyas, R.A.; Sapuan, S.M.; Ishak, M.R.; Zainudin, E.S.; Atikah, M.S.N. Characterization of sugar palm nanocellulose and its potential for reinforcement with a starch-based composite. In Sugar Palm Biofibers, Biopolymers, and Biocomposites, 1st ed.; CRC Press: Boca Raton, FL, USA, 2018; pp. 189–220. [Google Scholar]
- Ilyas, R.A.; Sapuan, S.M.; Sanyang, M.L.; Ishak, M.R. Nanocrystalline cellulose reinforced starch-based nanocomposite: A review. In Proceedings of the 5th Postgraduate Seminar on Natural Fiber Composites, Serdang, Selangor, Malaysia, 28 December 2016; Institute of Tropical Forestry and Forest Products (INTROP), Universiti Putra Malaysia: Serdang, Selangor, Malaysia, 2016; pp. 82–87. [Google Scholar]
- Ilyas, R.; Sapuan, S.M.; Ishak, M. Isolation and characterization of nanocrystalline cellulose from sugar palm fibres (Arenga pinnata). Carbohydr. Polym. 2018, 181, 1038–1051. [Google Scholar] [CrossRef]
- Jumaidin, R.; Ilyas, R.A.; Saiful, M.; Hussin, F.; Mastura, M.T. Water transport and physical properties of sugarcane bagasse fibre reinforced thermoplastic potato starch biocomposite. J. Adv. Res. Fluid Mech. Therm. Sci. 2019, 61, 273–281. [Google Scholar]
- Jumaidin, R.; Khiruddin, M.A.A.; Saidi, Z.A.S.; Salit, M.S.; Ilyas, R.A.; Sapuan, S.M. Effect of cogon grass fibre on the thermal, mechanical and biodegradation properties of thermoplastic cassava starch biocomposite. Int. J. Biol. Macromol. 2020, 146, 746–755. [Google Scholar] [CrossRef] [PubMed]
- Atikah, M.; Ilyas, R.; Sapuan, S.M.; Ishak, M.; Zainudin, E.; Ibrahim, R.; Atiqah, A.; Ansari, M.; Jumaidin, R. Degradation and physical properties of sugar palm starch/sugar palm nanofibrillated cellulose bionanocomposite. Polimery 2019, 64, 27–36. [Google Scholar] [CrossRef]
- Abral, H.; Ariksa, J.; Mahardika, M.; Handayani, D.; Aminah, I.; Sandrawati, N.; Sapuan, S.; Ilyas, R. Highly transparent and antimicrobial PVA based bionanocomposites reinforced by ginger nanofiber. Polym. Test. 2020, 81, 106186. [Google Scholar] [CrossRef]
- Nazrin, A.; Sapuan, S.M.; Zuhri, M.Y.M.; Ilyas, R.A.; Syafiq, R.; Sherwani, S.F.K. Nanocellulose reinforced thermoplastic starch (TPS), polylactic acid (PLA), and polybutylene succinate (PBS) for food packaging applications. Front. Chem. 2020, 8, 213. [Google Scholar] [CrossRef]
- Ayu, R.S.; Khalina, A.; Saffian, H.A.; Zaman, K.; Isma, T.; Liu, Q.; Ilyas, R.; Lee, C.H. Characterization study of empty fruit bunch (EFB) fibers reinforcement in poly(Butylene) succinate (PBS)/starch/glycerol composite sheet. Polymers 2020, 12, 1571. [Google Scholar] [CrossRef]
- Liang, R.; Xu, S.; Shoemaker, C.F.; Li, Y.; Zhong, F.; Huang, Q. Physical and antimicrobial properties of peppermint oil nanoemulsions. J. Agric. Food Chem. 2012, 60, 7548–7555. [Google Scholar] [CrossRef]
- Fernandes, R.V.D.B.; Borges, S.V.; Botrel, D.A. Gum arabic/starch/maltodextrin/inulin as wall materials on the microencapsulation of rosemary essential oil. Carbohydr. Polym. 2014, 101, 524–532. [Google Scholar] [CrossRef] [PubMed]
- Oriani, V.; Molina, G.; Chiumarelli, M.; Pastore, G.M.; Hubinger, M.D. Properties of cassava starch-based edible coating containing essential oils. J. Food Sci. 2014, 79, E189–E194. [Google Scholar] [CrossRef] [PubMed]
- Varona, S.; Rodriguez-Rojo, S.; Martin, A.; Cocero, M.J.; Duarte, C.M.; Alonso, M.J.C. Supercritical impregnation of lavandin (Lavandula hybrida) essential oil in modified starch. J. Supercrit. Fluids 2011, 58, 313–319. [Google Scholar] [CrossRef]
- Romani, V.P.; Prentice-Hernández, C.; Martins, V.G. Active and sustainable materials from rice starch, fish protein and oregano essential oil for food packaging. Ind. Crop. Prod. 2017, 97, 268–274. [Google Scholar] [CrossRef]
- Ghasemlou, M.; Aliheidari, N.; Fahmi, R.; Shojaee-Aliabadi, S.; Keshavarz, B.; Cran, M.J.; Khaksar, R. Physical, mechanical and barrier properties of corn starch films incorporated with plant essential oils. Carbohydr. Polym. 2013, 98, 1117–1126. [Google Scholar] [CrossRef]
- Caetano, K.D.S.; Lopes, N.A.; Costa, T.M.H.; Brandelli, A.; Rodrigues, E.; Flôres, S.H.; Cladera-Olivera, F. Characterization of active biodegradable films based on cassava starch and natural compounds. Food Packag. Shelf Life 2018, 16, 138–147. [Google Scholar] [CrossRef]
- Evangelho, J.A.D.; Dannenberg, G.; Biduski, B.; El Halal, S.L.M.; Kringel, D.H.; Gularte, M.A.; Fiorentini, Â.M.; Zavareze, E.D.R. Antibacterial activity, optical, mechanical, and barrier properties of corn starch films containing orange essential oil. Carbohydr. Polym. 2019, 222, 114981. [Google Scholar] [CrossRef]
- Sari, N.H.; Pruncu, C.I.; Sapuan, S.M.; Ilyas, R.A.; Catur, A.D.; Suteja, S.; Sutaryono, Y.A.; Pullen, G. The effect of water immersion and fibre content on properties of corn husk fibres reinforced thermoset polyester composite. Polym. Test. 2020, 91, 106751. [Google Scholar] [CrossRef]
- Norrrahim, M.N.F.; Sapuan, S.M.; Yasim-Anuar, T.A.T.; Padzil, F.N.M.; Sharip, N.S.; Ng, L.Y.F.; Megashah, L.N.; Shazleen, S.S.; Rahim, N.F.A.; Syafiq, R.; et al. Antimicrobial Studies on Food Packaging Materials. In Food Packaging, 1st ed.; Rangappa, S.M., Parameswaranpillai, J., Thiagamani, S.M.K., Krishnasamy, S., Siengchin, S., Eds.; CRC Press: Boca Raton, FL, USA, 2020; pp. 141–170. [Google Scholar]
- Restrepo, A.E.; Rojas, J.D.; Garcia, O.R.; Sanchez, L.T.; Pinzon, M.I.; Villa, C.C. Mechanical, barrier, and color properties of banana starch edible films incorporated with nanoemulsions of lemongrass (Cymbopogon citratus) and rosemary (Rosmarinus officinalis) essential oils. Food Sci. Technol. Int. 2018, 24, 705–712. [Google Scholar] [CrossRef]
- Campos-Requena, V.H.; Rivas, B.L.; Pérez, M.A.; Figueroa, C.R.; Figueroa, N.E.; Sanfuentes, E.A. Thermoplastic starch/clay nanocomposites loaded with essential oil constituents as packaging for strawberries—In vivo antimicrobial synergy over Botrytis cinerea. Postharvest Biol. Technol. 2017, 129, 29–36. [Google Scholar] [CrossRef]
- Suppakul, P.; Miltz, J.; Sonneveld, K.; Bigger, S.W. Antimicrobial properties of basil and its possible application in food packaging. J. Agric. Food Chem. 2003, 51, 3197–3207. [Google Scholar] [CrossRef] [PubMed]
- Campos-Requena, V.H.; Rivas, B.L.; Perez, M.A.; Garrido-Miranda, K.A.; Pereira, E.D. Release of essential oil constituent from thermoplastic starch/layered silicate bionanocomposite film as a potential active packaging material. Eur. Polym. J. 2018, 109, 64–71. [Google Scholar] [CrossRef]
- Sapuan, S.M.; Ilyas, R.A.; Ishak, M.R.; Leman, Z.; Huzaifah, M.R.M.; Ammar, I.M.; Atikah, M.S.N. Development of sugar palm–based products: A community project. In Sugar Palm Biofibers, Biopolymers, and Biocomposites, 1st ed.; CRC Press: Boca Raton, FL, USA, 2018; pp. 245–266. ISBN 9780429443923. [Google Scholar]
- Mohsenabadi, N.; Rajaei, A.; Tabatabaei, M.; Mohsenifar, A. Physical and antimicrobial properties of starch-carboxy methyl cellulose film containing rosemary essential oils encapsulated in chitosan nanogel. Int. J. Biol. Macromol. 2018, 112, 148–155. [Google Scholar] [CrossRef] [PubMed]
- Asrofi, M.; Sujito; Syafri, E.; Sapuan, S.; Ilyas, R. Improvement of biocomposite properties based tapioca starch and sugarcane bagasse cellulose nanofibers. Key Eng. Mater. 2020, 849, 96–101. [Google Scholar] [CrossRef]
- Azammi, A.M.N.; Ilyas, R.A.; Sapuan, S.M.; Ibrahim, R.; Atikah, M.S.N.; Asrofi, M.; Atiqah, A. Characterization studies of biopolymeric matrix and cellulose fibres based composites related to functionalized fibre-matrix interface. In Interfaces in Particle and Fibre Reinforced Composites; Elsevier: London, UK, 2020; pp. 29–93. ISBN 9780081026656. [Google Scholar]
- Jumaidin, R.; Saidi, Z.A.S.; Ilyas, R.A.; Ahmad, M.N.; Wahid, M.K.; Yaakob, M.Y.; Maidin, N.A.; Rahman, M.H.A.; Osman, M.H. Characteristics of cogon grass fibre reinforced thermoplastic cassava starch biocomposite: Water absorption and physical properties. J. Adv. Res. Fluid Mech. Therm. Sci. 2019, 62, 43–52. [Google Scholar]
- Silva, A.D.O.D.; Cortez-Vega, W.R.; Prentice, C.; Fonseca, G.G. Development and characterization of biopolymer films based on bocaiuva (Acromonia aculeata) flour. Int. J. Biol. Macromol. 2020, 155, 1157–1168. [Google Scholar] [CrossRef]
- Cox, S.D.; Mann, C.M.; Markham, J.L.; Bell, H.C.; Gustafson, J.E.; Warmington, J.R.; Wyllie, S.G. The mode of antimicrobial action of the essential oil of Melaleuca alternifolia (tea tree oil). J. Appl. Microbiol. 2000, 88, 170–175. [Google Scholar] [CrossRef]
- Almasi, H.; Azizi, S.; Amjadi, S. Development and characterization of pectin films activated by nanoemulsion and Pickering emulsion stabilized marjoram (Origanum majorana L.) essential oil. Food Hydrocoll. 2020, 99, 105338. [Google Scholar] [CrossRef]
- De Andrade, M.F.; Silva, I.D.D.L.; Da Silva, G.A.; Cavalcante, P.V.D.; Da Silva, F.T.; De Almeida, Y.M.B.; Vinhas, G.M.; De Carvalho, L.H. A study of poly (butylene adipate-co-terephthalate)/orange essential oil films for application in active antimicrobial packaging. LWT 2020, 125, 109148. [Google Scholar] [CrossRef]
- Klimek-Szczykutowicz, M.; Szopa, A.; Ekiert, H. Citrus limon (lemon) phenomenon—A review of the chemistry, pharmacological properties, applications in the modern pharmaceutical, food, and cosmetics industries, and biotechnological studies. Plants 2020, 9, 119. [Google Scholar] [CrossRef]
- Feyaerts, A.F.; Luyten, W.; Van Dijck, P. Striking essential oil: Tapping into a largely unexplored source for drug discovery. Sci. Rep. 2020, 10, 2867. [Google Scholar] [CrossRef] [PubMed]
- Cruz-Tirado, J.; Ferreira, R.S.B.; Lizárraga, E.; Tapia-Blácido, D.R.; Silva, N.; Angelats-Silva, L.; Siche, R. Bioactive Andean sweet potato starch-based foam incorporated with oregano or thyme essential oil. Food Packag. Shelf Life 2020, 23, 100457. [Google Scholar] [CrossRef]
- Taban, A.; Saharkhiz, M.J.; Khorram, M. Formulation and assessment of nano-encapsulated bioherbicides based on biopolymers and essential oil. Ind. Crop. Prod. 2020, 149, 112348. [Google Scholar] [CrossRef]
- Zerrifi, S.E.A.; Kasrati, A.; Redouane, E.M.; Tazart, Z.; El Khalloufi, F.; Abbad, A.; Oudra, B.; Campos, A.; Vasconcelos, V. Essential oils from Moroccan plants as promising ecofriendly tools to control toxic cyanobacteria blooms. Ind. Crop. Prod. 2020, 143, 111922. [Google Scholar] [CrossRef]
- Ataei, S.; Azari, P.; Hassan, A.; Pingguan-Murphy, B.; Yahya, R.; Muhamad, F. Essential oils-loaded electrospun biopolymers: A future perspective for active food packaging. Adv. Polym. Technol. 2020, 2020, 9040535. [Google Scholar] [CrossRef]
- Doost, A.S.; Nasrabadi, M.N.; Kassozi, V.; Nakisozi, H.; Van Der Meeren, P. Recent advances in food colloidal delivery systems for essential oils and their main components. Trends Food Sci. Technol. 2020, 99, 474–486. [Google Scholar] [CrossRef]
- Esmael, A.; Hassan, M.G.; Amer, M.M.; Abdelrahman, S.; Hamed, A.M.; Abd-Raboh, H.A.; Foda, M.F. Antimicrobial activity of certain natural-based plant oils against the antibiotic-resistant acne bacteria. Saudi J. Biol. Sci. 2020, 27, 448–455. [Google Scholar] [CrossRef]
- Song, X.; Zuo, G.; Chen, F. Effect of essential oil and surfactant on the physical and antimicrobial properties of corn and wheat starch films. Int. J. Biol. Macromol. 2018, 107, 1302–1309. [Google Scholar] [CrossRef]
- Iamareerat, B.; Singh, M.; Sadiq, M.B.; Anal, A.K. Reinforced cassava starch based edible film incorporated with essential oil and sodium bentonite nanoclay as food packaging material. J. Food Sci. Technol. 2018, 55, 1953–1959. [Google Scholar] [CrossRef]
- Jamróz, E.; Juszczak, L.; Kucharek, M. Investigation of the physical properties, antioxidant and antimicrobial activity of ternary potato starch-furcellaran-gelatin films incorporated with lavender essential oil. Int. J. Biol. Macromol. 2018, 114, 1094–1101. [Google Scholar] [CrossRef]
- Helal, I.; El-Bessoumy, A.; Al-Bataineh, E.; Joseph, M.R.P.; Rajagopalan, P.; Chandramoorthy, H.C.; Ahmed, S.B.H. Antimicrobial efficiency of essential oils from traditional medicinal plants of asir region, saudi arabia, over drug resistant isolates. BioMed Res. Int. 2019, 2019, 8928306. [Google Scholar] [CrossRef] [PubMed]
- Ferreira, L.R.; Rosário, D.K.A.; Silva, P.I.; Carneiro, J.C.S.; Pimentel Filho, N.J.; Bernardes, P.C. Cinnamon essential oil reduces adhesion of food pathogens to polystyrene. Int. Food Res. J. 2019, 26, 1103–1110. [Google Scholar]
- Silveira, M.P.; Silva, H.C.; Pimentel, I.C.; Poitevin, C.G.; Stuart, A.K.D.C.; Carpiné, D.; Jorge, L.M.D.M.; Jorge, R.M.M. Development of active cassava starch cellulose nanofiber-based films incorporated with natural antimicrobial tea tree essential oil. J. Appl. Polym. Sci. 2020, 137, 48726. [Google Scholar] [CrossRef]
- Utami, R.; Khasanah, L.U.; Manuhara, G.J.; Ayuningrum, Z.K. Effects of cinnamon bark essential oil (Cinnamomum burmannii) on characteristics of edible film and quality of fresh beef. Pertanika J. Trop. Agric. Sci. 2019, 42, 1173–1184. [Google Scholar]
- Sarifuddin, N.; Shahrim, N.A.A.; Azman, K.S. Effect of oregano essential on the properties of mango kernel starch films. MS&E 2018, 429, 012062. [Google Scholar] [CrossRef]
- Chouhan, S.; Sharma, K.; Guleria, S. Antimicrobial activity of some essential oils—Present status and future perspectives. Medicines 2017, 4, 58. [Google Scholar] [CrossRef]
- Sapper, M.; Wilcaso, P.; Santamarina, M.P.; Roselló, J.; Chiralt, A. Antifungal and functional properties of starch-gellan films containing thyme (Thymus zygis) essential oil. Food Control 2018, 92, 505–515. [Google Scholar] [CrossRef]
- Saad, N.; Muller, C.D.; Lobstein, A. Major bioactivities and mechanism of action of essential oils and their components. Flavour Fragr. J. 2013, 28, 269–279. [Google Scholar] [CrossRef]
- Li, Z.H.; Sun, P.; Liu, Y.S.; Sun, P.; Luo, S.L. Antibacterial Activity and Mechanisms of Essential Oil from Citrus medica L. var. sarcodactylis. Molecules 2019, 24, 1577. [Google Scholar] [CrossRef]
- Tao, C.; Wang, Y.; Zhang, X.; Li, L.; Wu, Y. Mechanism of action of essential oils extracted from bamboo (phyllostachys heterocycla cv. pubescens) leaves: Chemical composition and antimicrobial activity. BioResources 2019, 14, 1419–1434. [Google Scholar] [CrossRef]
- Ochs, D. Antimicrobials. In Plastic Additives Handbook; Hanser: Munich, Germany, 2000; pp. 647–680. [Google Scholar]
- Appendini, P.; Hotchkiss, J. Review of antimicrobial food packaging. Innov. Food Sci. Emerg. Technol. 2002, 3, 113–126. [Google Scholar] [CrossRef]
- Zeuthen, P.; Bøgh-Sørensen, L. Food Preservation Techniques; Elsevier: Amsterdam, The Netherlands, 2003. [Google Scholar]
- Avila-Sosa, R.; Hernández-Zamoran, E.; López-Mendoza, I.; Palou, E.; Jiménez-Munguía, M.T.; Nevárez-Moorillon, G.; López-Malo, A. Fungal inactivation by Mexican oregano (lippia berlandieri schauer) essential oil added to amaranth, chitosan, or starch edible films. J. Food Sci. 2010, 75, M127–M133. [Google Scholar] [CrossRef] [PubMed]
- Cano, A.; Cháfer, M.; Chiralt, A.; González-Martínez, C. Physical and antimicrobial properties of starch-pva blend films as affected by the incorporation of natural antimicrobial agents. Foods 2016, 5, 3. [Google Scholar] [CrossRef] [PubMed]
- Aitboulahsen, M.; El Galiou, O.; Laglaoui, A.; Bakkali, M.; Zerrouk, M.H. Effect of plasticizer type and essential oils on mechanical, physicochemical, and antimicrobial characteristics of gelatin, starch, and pectin-based films. J. Food Process. Preserv. 2020, 44, e14480. [Google Scholar] [CrossRef]
- Mustapha, F.; Jai, J.; Raikhan, N.N.; Sharif, Z.; Yusof, N. Response surface methodology analysis towards biodegradability and antimicrobial activity of biopolymer film containing turmeric oil against Aspergillus niger. Food Control 2019, 99, 106–113. [Google Scholar] [CrossRef]
- Liakos, I.L.; Rizzello, L.; Scurr, D.J.; Pompa, P.P.; Bayer, I.; Athanassiou, A. All-natural composite wound dressing films of essential oils encapsulated in sodium alginate with antimicrobial properties. Int. J. Pharm. 2014, 463, 137–145. [Google Scholar] [CrossRef]
- Aldana, D.S.; Andrade-Ochoa, S.; Aguilar-González, C.N.; Contreras-Esquivel, J.C.; Nevárez-Moorillon, G. Antibacterial activity of pectic-based edible films incorporated with Mexican lime essential oil. Food Control 2015, 50, 907–912. [Google Scholar] [CrossRef]
- Hosseini, S.F.; Rezaei, M.; Zandi, M.; Farahmandghavi, F. Development of bioactive fish gelatin/chitosan nanoparticles composite films with antimicrobial properties. Food Chem. 2016, 194, 1266–1274. [Google Scholar] [CrossRef]
- Shahbazi, Y. The properties of chitosan and gelatin films incorporated with ethanolic red grape seed extract and Ziziphora clinopodioides essential oil as biodegradable materials for active food packaging. Int. J. Biol. Macromol. 2017, 99, 746–753. [Google Scholar] [CrossRef]
- Lee, J.Y.; Garcia, C.V.; Shin, G.H.; Kim, J.T. Antibacterial and antioxidant properties of hydroxypropyl methylcellulose-based active composite films incorporating oregano essential oil nanoemulsions. LWT 2019, 106, 164–171. [Google Scholar] [CrossRef]
- Rojas-Graü, M.A.; Avena-Bustillos, R.J.; Olsen, C.; Friedman, M.; Henika, P.R.; Martín-Belloso, O.; Pan, Z.; McHugh, T. Effects of plant essential oils and oil compounds on mechanical, barrier and antimicrobial properties of alginate–apple puree edible films. J. Food Eng. 2007, 81, 634–641. [Google Scholar] [CrossRef]
- Nazari, M.; Majdi, H.; Milani, M.; Abbaspour, S.; Hamishehkar, H.; Lim, L.T. Cinnamon nanophytosomes embedded electrospun nanofiber: Its effects on microbial quality and shelf-life of shrimp as a novel packaging. Food Packag. Shelf Life 2019, 21, 100349. [Google Scholar] [CrossRef]
- Dashipour, A.; Razavilar, V.; Hosseini, H.; Shojaee-Aliabadi, S.; German, J.B.; Ghanati, K.; Khakpour, M.; Khaksar, R. Antioxidant and antimicrobial carboxymethyl cellulose films containing Zataria multiflora essential oil. Int. J. Biol. Macromol. 2015, 72, 606–613. [Google Scholar] [CrossRef] [PubMed]
- Ilyas, R.A.; Sapuan, S.M.; Ibrahim, R.; Abral, H.; Ishak, M.; Zainudin, E.; Asrofi, M.; Atikah, M.S.N.; Huzaifah, M.R.M.; Radzi, A.M.; et al. Sugar palm (Arenga pinnata (Wurmb.) Merr) cellulosic fibre hierarchy: A comprehensive approach from macro to nano scale. J. Mater. Res. Technol. 2019, 8, 2753–2766. [Google Scholar] [CrossRef]
- Ilyas, R.A.; Sapuan, S.M.; Ishak, M.R.; Zainudin, E.S. Effect of delignification on the physical, thermal, chemical, and structural properties of sugar palm fibre. BioResources 2017, 12, 8734–8754. [Google Scholar] [CrossRef]
- Ilyas, R.A.; Sapuan, S.M.; Sanyang, M.L.; Ishak, M.R.; Zainudin, E.S. Nanocrystalline cellulose as reinforcement for polymeric matrix nanocomposites and its potential applications: A review. Curr. Anal. Chem. 2018, 14, 203–225. [Google Scholar] [CrossRef]
- Ilyas, R.; Sapuan, S.M.; Ishak, M.; Zainudin, E.S. Sugar palm nanofibrillated cellulose (Arenga pinnata (Wurmb.) Merr): Effect of cycles on their yield, physic-chemical, morphological and thermal behavior. Int. J. Biol. Macromol. 2019, 123, 379–388. [Google Scholar] [CrossRef]
- Ilyas, R.; Sapuan, S.M.; Ibrahim, R.; Abral, H.; Ishak, M.; Zainudin, E.; Atikah, M.; Nurazzi, N.M.; Atiqah, A.; Ansari, M.; et al. Effect of sugar palm nanofibrillated cellulose concentrations on morphological, mechanical and physical properties of biodegradable films based on agro-waste sugar palm (Arenga pinnata (Wurmb.) Merr) starch. J. Mater. Res. Technol. 2019, 8, 4819–4830. [Google Scholar] [CrossRef]
- Ilyas, R.A.; Sapuan, S.M.; Ibrahim, R.; Abral, H.; Ishak, M.R.; Zainudin, E.S.; Atiqah, A.; Atikah, M.S.N.; Syafri, E.; Asrofi, M.; et al. Thermal, biodegradability and water barrier properties of bio-nanocomposites based on plasticised sugar palm starch and nanofibrillated celluloses from sugar palm fibres. J. Biobased Mater. Bioenergy 2020, 14, 234–248. [Google Scholar] [CrossRef]
- Brinchi, L.; Cotana, F.; Fortunati, E.; Kenny, J.M. Production of nanocrystalline cellulose from lignocellulosic biomass: Technology and applications. Carbohydr. Polym. 2013, 94, 154–169. [Google Scholar] [CrossRef]
- De Azeredo, H.M.C.; Rosa, M.D.F.; Mattoso, L.H.C. Nanocellulose in bio-based food packaging applications. Ind. Crop. Prod. 2017, 97, 664–671. [Google Scholar] [CrossRef]
- Kian, L.; Saba, N.; Jawaid, M.; Sultan, M. A review on processing techniques of bast fibers nanocellulose and its polylactic acid (PLA) nanocomposites. Int. J. Biol. Macromol. 2019, 121, 1314–1328. [Google Scholar] [CrossRef] [PubMed]
- Ilyas, R.A.; Sapuan, S.M.; Ishak, M.R.; Zainudin, E.S. Water transport properties of bio-nanocomposites reinforced by sugar palm (Arenga pinnata) nanofibrillated cellulose. J. Adv. Res. Fluid Mech. Therm. Sci. J. 2018, 51, 234–246. [Google Scholar]
- Gao, W.; Wu, W.; Liu, P.; Hou, H.; Li, X.; Cui, B. Preparation and evaluation of hydrophobic biodegradable films made from corn/octenylsuccinated starch incorporated with different concentrations of soybean oil. Int. J. Biol. Macromol. 2020, 142, 376–383. [Google Scholar] [CrossRef] [PubMed]
- Salarbashi, D.; Tajik, S.; Ghasemlou, M.; Shojaee-Aliabadi, S.; Noghabi, M.S.; Khaksar, R. Characterization of soluble soybean polysaccharide film incorporated essential oil intended for food packaging. Carbohydr. Polym. 2013, 98, 1127–1136. [Google Scholar] [CrossRef]
- Shaili, T.; Abdorreza, M.N.; Fariborz, N. Functional, thermal, and antimicrobial properties of soluble soybean polysaccharide biocomposites reinforced by nano TiO2. Carbohydr. Polym. 2015, 134, 726–731. [Google Scholar] [CrossRef]
- Akhter, R.; Masoodi, F.; Wani, T.A.; Rather, S.A. Functional characterization of biopolymer based composite film: Incorporation of natural essential oils and antimicrobial agents. Int. J. Biol. Macromol. 2019, 137, 1245–1255. [Google Scholar] [CrossRef]
- Ghanbarzadeh, B.; Almasi, H.; Entezami, A.A. Improving the barrier and mechanical properties of corn starch-based edible films: Effect of citric acid and carboxymethyl cellulose. Ind. Crop. Prod. 2011, 33, 229–235. [Google Scholar] [CrossRef]
- Li, X.; Qiu, C.; Ji, N.; Sun, C.; Xiong, L.; Sun, Q. Mechanical, barrier and morphological properties of starch nanocrystals-reinforced pea starch films. Carbohydr. Polym. 2015, 121, 155–162. [Google Scholar] [CrossRef]
- Jansson, A.; Järnström, L. Barrier and mechanical properties of modified starches. Cellulose 2005, 12, 423–433. [Google Scholar] [CrossRef]
- PirouziFard, M.; Yorghanlu, R.A.; Pirsa, S. Production of active film based on potato starch containing Zedo gum and essential oil of Salvia officinalis and study of physical, mechanical, and antioxidant properties. J. Thermoplast. Compos. Mater. 2019, 33, 915–937. [Google Scholar] [CrossRef]
- Djunaedy, A. Systemic fungicide applications and utilization of mycorrhizae in the framework of the soil control of plant pathogens tular soybean (Glycine max L.). Embryo 2008, 5, 1–9. [Google Scholar]
- Costa, S.S.; Druzian, J.I.; Machado, B.A.S.; De Souza, C.O.; Gil Guimarães, A. Bi-functional biobased packing of the cassava starch, glycerol, licuri nanocellulose and red propolis. PLoS ONE 2014, 9, e112554. [Google Scholar] [CrossRef]
- Da Silva, J.B.; Pereira, F.V.; Druzian, J.I. Cassava starch-based films plasticized with sucrose and inverted sugar and reinforced with cellulose nanocrystals. J. Food Sci. 2012, 77, 14–19. [Google Scholar] [CrossRef]
- Mathlouthi, M. Water content, water activity, water structure and the stability of foodstuffs. Food Control 2001, 12, 409–417. [Google Scholar] [CrossRef]
- Ilyas, R. Biopolymers and biocomposites: Chemistry and technology. Curr. Anal. Chem. 2020, 16, 500–503. [Google Scholar] [CrossRef]
- Ilyas, R.A.; Sapuan, S.M.; Kadier, A.; Kalil, M.S.; Ibrahim, R.; Atikah, M.S.N.; Nurazzi, N.M.; Nazrin, A.; Lee, C.H.; Faiz Norrrahim, M.N.; et al. Properties and characterization of PLA, PHA, and other types of biopolymer composites. In Advanced Processing, Properties, and Applications of Starch and Other Bio-Based Polymers; Al-Oqla, F., Sapuan, S.M., Eds.; Elsevier: Amsterdam, The Netherlands, 2020; pp. 111–138. [Google Scholar]
- Lee, C.H.; Sapuan, S.M.; Ilyas, R.A.; Lee, S.H.; Khalina, A. Development and processing of PLA, PHA, and other biopolymers. In Advanced Processing, Properties, and Applications of Starch and Other Bio-Based Polymers; Al-Oqla, F., Sapuan, S.M., Eds.; Elsevier: Amsterdam, The Netherlands, 2020; pp. 47–63. [Google Scholar]
- Ilyas, R.A.; Sapuan, S.M.; Norrrahim, M.N.F.; Yasim-Anuar, T.A.T.; Kadier, A.; Kalil, M.S.; Atikah, M.S.N.; Ibrahim, R.; Asrofi, M.; Abral, H.; et al. Nanocellulose/starch biopolymer nanocomposites: Processing, manufacturing, and applications. In Advanced Processing, Properties, and Applications of Starch and Other Bio-Based Polymers; Al-Oqla, F., Sapuan, S.M., Eds.; Elsevier: Amsterdam, The Netherlands, 2020; pp. 65–88. [Google Scholar]
- Ilyas, R.A.; Sapuan, S.M.; Kadier, A.; Krishnan, S.; Atikah, M.S.N.; Ibrahim, R.; Nazrin, A.; Syafiq, R.; Misri, S.; Huzaifah, M.R.M.; et al. Mechanical testing of sugar palm fiber reinforced sugar palm biopolymer composites. In Advanced Processing, Properties, and Applications of Starch and Other Bio-Based Polymers; Al-Oqla, F., Sapuan, S.M., Eds.; Elsevier: Amsterdam, The Netherlands, 2020; pp. 89–110. [Google Scholar]
- De-Melo, A.A.M.; Silveira, M.F.A.; Torres, M.C.L.; Rezende, C.S.M.E.; Fernandes, T.H.; De Oliveira, A.N.; Geraldine, R.M. Microbiological quality and other characteristics of refrigerated chicken meat in contact with cellulose acetate-based film incorporated with rosemary essential oil. Braz. J. Microbiol. 2012, 43, 1419–1427. [Google Scholar] [CrossRef]
- Peng, Y.; Li, Y. Combined effects of two kinds of essential oils on physical, mechanical and structural properties of chitosan films. Food Hydrocoll. 2014, 36, 287–293. [Google Scholar] [CrossRef]
- Oussalah, M.; Caillet, S.; Salmiéri, S.; Saucier, L.; Lacroix, M. Antimicrobial Effects of alginate-based films containing essential oils on listeria monocytogenes and salmonella typhimurium present in bologna and ham. J. Food Prot. 2007, 70, 901–908. [Google Scholar] [CrossRef]
- Sanchez-Gonzalez, L.; Pastor, C.; Vargas, M.; Chiralt, A.; Gonzalez-Martinez, C.; Chafer, M. Effect of hydroxypropylmethylcellulose and chitosan coatings with and without bergamot essential oil on quality and safety of cold-stored grapes. Postharvest Biol. Technol. 2011, 60, 57–63. [Google Scholar] [CrossRef]
- Seydim, A.C.; Sarikus, G. Antimicrobial activity of whey protein based edible films incorporated with oregano, rosemary and garlic essential oils. Food Res. Int. 2006, 39, 639–644. [Google Scholar] [CrossRef]
- Jouki, M.; Yazdi, F.T.; Mortazavi, S.A.; Koocheki, A. Quince seed mucilage films incorporated with oregano essential oil: Physical, thermal, barrier, antioxidant and antibacterial properties. Food Hydrocoll. 2014, 36, 9–19. [Google Scholar] [CrossRef]
- Botre, D.A.; Soares, N.D.F.F.; Espitia, P.J.P.; De Sousa, S.; Renhe, I.R.T. Avaliação de filme incorporado com óleo essencial de orégano para conservação de pizza pronta. Rev. Ceres 2010, 57, 283–291. [Google Scholar] [CrossRef][Green Version]
- Otero, V.; Becerril, R.; Santos, J.A.; Rodríguez-Calleja, J.M.; Nerín, C.; García, M. Evaluation of two antimicrobial packaging films against Escherichia coli O157:H7 strains in vitro and during storage of a Spanish ripened sheep cheese (Zamorano). Food Control 2014, 42, 296–302. [Google Scholar] [CrossRef]
- Emiroğlu, Z.K.; Yemiş, G.P.; Coşkun, B.K.; Candoğan, K. Antimicrobial activity of soy edible films incorporated with thyme and oregano essential oils on fresh ground beef patties. Meat Sci. 2010, 86, 283–288. [Google Scholar] [CrossRef]
- Zinoviadou, K.G.; Koutsoumanis, K.P.; Biliaderis, C.G. Physico-chemical properties of whey protein isolate films containing oregano oil and their antimicrobial action against spoilage flora of fresh beef. Meat Sci. 2009, 82, 338–345. [Google Scholar] [CrossRef]
- Takala, P.N.; Vu, K.D.; Salmieri, S.; Khan, R.A.; Lacroix, M. Antibacterial effect of biodegradable active packaging on the growth of Escherichia coli, Salmonella typhimurium and Listeria monocytogenes in fresh broccoli stored at 4 °C. LWT Food Sci. Technol. 2013, 53, 499–506. [Google Scholar] [CrossRef]
- Tongnuanchan, P.; Benjakul, S.; Prodpran, T. Physico-chemical properties, morphology and antioxidant activity of film from fish skin gelatin incorporated with root essential oils. J. Food Eng. 2013, 117, 350–360. [Google Scholar] [CrossRef]
- Shojaee-Aliabadi, S.; Hosseini, H.; Mohammadifar, M.A.; Mohammadi, A.; Ghasemlou, M.; Ojagh, S.M.; Hosseini, S.M.; Khaksar, R. Characterization of antioxidant-antimicrobial κ-carrageenan films containing Satureja hortensis essential oil. Int. J. Biol. Macromol. 2013, 52, 116–124. [Google Scholar] [CrossRef]
- Oussalah, M.; Caillet, S.; Salmiéri, S.; Saucier, L.; Lacroix, M. Antimicrobial and antioxidant effects of milk protein-based film containing essential oils for the preservation of whole beef muscle. J. Agric. Food Chem. 2004, 52, 5598–5605. [Google Scholar] [CrossRef]
- Gómez-Estaca, J.; De Lacey, A.L.; López-Caballero, M.; Gómez-Guillén, M.; Montero, P. Biodegradable gelatin–chitosan films incorporated with essential oils as antimicrobial agents for fish preservation. Food Microbiol. 2010, 27, 889–896. [Google Scholar] [CrossRef] [PubMed]
- Salgado, P.R.; López-Caballero, M.E.; Gómez-Guillén, M.C.; Mauri, A.N.; Montero, M.P. Sunflower protein films incorporated with clove essential oil have potential application for the preservation of fish patties. Food Hydrocoll. 2013, 33, 74–84. [Google Scholar] [CrossRef]
- Choi, W.S.; Singh, S.; Lee, Y.S.; Choi, W.S. Characterization of edible film containing essential oils in hydroxypropyl methylcellulose and its effect on quality attributes of ‘Formosa’ plum (Prunus salicina L.). LWT 2016, 70, 213–222. [Google Scholar] [CrossRef]
- Yun, J.; Fan, X.; Li, X.; Jin, T.Z.; Jia, X.; Mattheis, J.P. Natural surface coating to inactivate Salmonella enterica serovar Typhimurium and maintain quality of cherry tomatoes. Int. J. Food Microbiol. 2015, 193, 59–67. [Google Scholar] [CrossRef] [PubMed]
- Vu, K.; Hollingsworth, R.; Leroux, E.; Salmieri, S.; Lacroix, M. Development of edible bioactive coating based on modified chitosan for increasing the shelf life of strawberries. Food Res. Int. 2011, 44, 198–203. [Google Scholar] [CrossRef]
- Perdones, Á.; Escriche, I.; Chiralt, A.; Vargas, M. Effect of chitosan–lemon essential oil coatings on volatile profile of strawberries during storage. Food Chem. 2016, 197, 979–986. [Google Scholar] [CrossRef]

| EOs | Diameter of Inhibitory Zone (mm) | ||
|---|---|---|---|
| Bacteria | |||
| Staphylococcus aureus (SA) | Escherichia coli (EC) | Salmonella enterica (SE) | |
| Cinnamon | 18.2 ± 1.8 | 19.7 ± 1.8 | 15.5 ± 2.8 |
| Pepper mint | 12.4 ± 2.3 | 5.8 ± 0.3 | NA |
| Rosemary | 9.6 ± 2.5 | 7.9 ± 1.8 | 9.0 ± 1.2 |
| Sweet orange | 7.8 ± 0.6 | 8.7 ± 1.4 | 7.9 ± 0.7 |
| Tahiti lemon | 6.8 ± 0.4 | NA | NA |
| Ginger | 6.0 ± 2.2 | NA | NA |
| Starch | EOs | Inhibition Zone (%) | References | |
|---|---|---|---|---|
| S. aureus Gram (+) | E. coli Gram (-) | |||
| Corn/Wheat | Lemon | 47.72 ± 2.87 | 45.56 ± 3.15 | [56] |
| Corn/Wheat | Lemon | 45.89 ± 3.36 | 45.34 ± 3.48 | [56] |
| L. monocytogenes | ||||
| Modified Starch | Peppermint oil | - | - | [25] |
| P. commune | E. amstelodami | |||
| Cassava | Cinnamon | 25.94 ± 5.72 | 91.06 ± 15.48 | [7] |
| Escherichia coli | S. aureus | |||
| Cassava | Cinnamon | 12.17 ± 0.29 | 11.17 ± 0.29 | [57] |
| E.coli ATCC 25922 | S.aureus ATCC 25923 | |||
| Potato | Lavender | - | - | [58] |
| Aspergillus niger | Penicillium spp. | |||
| Amaranth/Chitosan/Starch | Mexican Oregano | - | - | [72] |
| A. niger | P. expansum | |||
| Pea | Oregano | - | - | [73] |
| Pea | Neem | 4.35 ± 0.10 | 4.34 ± 0.06 | [73] |
| Pseudomonas fluorescens | Aspergillus niger | |||
| Cassava | Lemon Grass (0.5%) | 25.89 ± 0.12 | 11.97 ± 0.176 | [1] |
| S. aureus Gram (+) | Candida albicans | |||
| Cassava | Tea tree (TTO) (1.5%) | 77 ± 0.24 | 65 ± 0.24 | [61] |
| Pseudomonas fluorescens | ||||
| Tapioca | Cinnamon bark (2.0%) | 28.6 ± 0.85 | [62] | |
| S. aureus | L. monocytogenes | |||
| Potato | Lavandula angustifolia (0.5%) | 13.69 ± 0.89 | 17.25 ± 0.59 | [74] |
| Potato | Mentha pulegium (0.5%) | 21.01 ± 0.42 | 22.90 ± 0.90 | [74] |
| A. niger | ||||
| Cassava | Tumeric (0.5%) | 17.02 ± 0.42 | [75] | |
| Escherichia coli | Candida albicans | |||
| Sodium Alginate (NaAlg) | Cinnamon (50%) | 6 ± 0.12 | 13 ± 0.06 | [76] |
| Lavender (50%) | 0.5 ± 0.89 | 2 0.90 | ||
| Tea tree (50%) | 0.5 ± 0.59 | 1.5 ± 0.10 | ||
| Peppermint (50%) | 1 ± 0.06 | 2 ± 0.12 | ||
| Escherichia coli | S. aureus | |||
| lime bagasse pectic extract | Lime (0.5%) | 11.8 ± 1.0 | 13.5 ± 0.8 | [77] |
| lime pomace pectic extract | Lime (0.5%) | 9.5 ± 0.9 | 8.3 ± 0.8 | |
| Escherichia coli | S. aureus | |||
| Fish gelatin/Chitosan nanoparticle | Origanum vulgare L. (1.2%) | 33.00 ± 1.00 | 26.33 ± 0.57 | [78] |
| B. Subtilis | S. aureus | |||
| Chitosan | Ziziphora clinopodioides (1%) | 5.4 ± 0.1 | 6.1 ± 0.1 | [79] |
| Grape seed (1%) | 1.7 ± 0.1 | 3.1 ± 0.1 | ||
| Gelatin | Ziziphora clinopodioides (1%) | 4.3 ± 0.2 | 5.6 ± 0.1 | |
| Grape seed (1%) | 1.3 ± 0.1 | 2.1 ± 0.1 | ||
| Escherichia coli | S. aureus | |||
| Hydroxypropyl methylcellulose (HPMC) | Oregano (0.75%) | 31.22 ± 0.24 | 35.46 ± 0.33 | [80] |
| Escherichia coli | ||||
| Alginate–apple puree | Oregano (0.1%) | 49.8 | [81] | |
| Cinnamon (0.5%) | 40.8 | |||
| Lemongrass (0.5%) | 19.6 | |||
| Escherichia coli | S. aureus | |||
| Polyvinyl alcohol nanofibre | Cinnamon nanophytosome (5%) | 12 ± 0.82 | 12 ± 2.12 | [82] |
| Escherichia coli | S. aureus | |||
| Carboxymethyl cellulose | Zataria multiflora Boiss (3%) | 56.33 ± 1.52 | 57.66 ± 1.15 | [83] |
| Starch | EOs | Moisture Content (%) | Water Vapor Permeability (g−1·s−1·Pa−1) | Tensile Strength (MPa) | Tensile Modulus (MPa) | Elongation % | References |
|---|---|---|---|---|---|---|---|
| Corn/Wheat | Lemon | 16.2 ± 0.29 | 3.28 ± 0.06 | 11.16 ± 1.03 | - | 26.50 ± 0.39 | [56] |
| Corn/Wheat | Lemon | 11.0 ± 0.33 | 3.07 ± 0.08 | 11.50 ± 1.06 | - | 32.20 ± 0.55 | [56] |
| Cassava | Cinnamon | - | 9.78 ± 1.46 | 1.05 ± 0.16 | - | 191.27 ± 22.62 | [7] |
| Cassava | Cinnamon (1.5%) | - | 14.79 ± 2.76 | 0.63 ± 0.09 | - | 108.85 ± 7.29 | [57] |
| Potato | Lavender (2%) | 72.28 ± 9.75 | - | 62.8 ± 1.9 | - | 19.5 ± 2.6 | [58] |
| Pea | Oregano | 4.33 ± 0.13 | 4.9 ± 0.5 | 26 ± 2.0 | 502 ± 50 | 42 ± 11 | [73] |
| Pea | Neem | 6.7 ± 0.13 | 4.1 ± 0.4 | 21.5 ± 1.0 | 413 ± 32 | 44 ± 7 | [73] |
| Cassava | Lemon Grass (0.5%) | - | 23.28 ± 1.17 | 0.52 ± 0.022 | - | 30.02 ± 1.46 | [1] |
| Cassava | Tea tree (1.5%) | 9.958 ± 1.20 | 3.03 ± 0.46 | 25.1 ± 2.8 | [61] | ||
| Tapioca | Cinnamon bark (2.0%) | 21.38 ± 1.29 | 1.23 ± 0.09 | 58.56 ± 1.23 | [62] | ||
| Corn/octenylsuccinated | Soybean (0.5%) | 2.72 ± 0.13 | 5.21 ± 0.20 | 36.54 ± 6.36 | [94] | ||
| Potato | Lavandula angustifolia (0.5%) | 2.65 ± 0.07 | 45.88 ± 1.19 | 15.33 ± 0.15 | [74] | ||
| Potato | Mentha pulegium (0.5%) | 2.59 ± 0.43 | 36.15 ± 1.91 | 17.63 ± 2.42 | [74] | ||
| Soybean | Zataria multi- flora Boiss (ZEO) (3%) | 18.92 ± 0.53 | 1.2 ± 0.05 | 8.43 ± 0.43 | 40.66 ± 0.74 | [95] | |
| Soybean | Mentha pulegium (MEO) (3%) | 27.02 ± 2.07 | 1.7 ± 0.03 | 6.72 ± 0.56 | 38.73 ± 0.36 | [95] | |
| Soybean | nano titanium dioxide (TiO2-N) (3%) | 5.27 ± 0.17 | 17.22 ± 0.42 | 0.332 ± 0.032 | 22.2 ± 4.3 | [96] | |
| Chitosan | Mint oil (0.5%) | 10.98 ± 0.18 | 0.028 ± 0.004 | 16.99 ± 0.46 | 1.14 ± 0.60 | 14.87 ± 0.34 | [97] |
| Chitosan | Rosemary oil (0.5%) | 5.08 ± 0.50 | 0.014 ± 0.001 | 25.95 ± 0.48 | 1.42 ± 0.53 | 18.20 ± 0.30 | [97] |
| Fish gelatin/Chitosan nanoparticle | Origanum vulgare L. (1.2%) | 0.683 ± 0.050 | 3.28 ± 0.43 | 153.75 ± 25.24 | 87.20 ± 17.14 | [78] | |
| Chitosan | Ziziphora clinopodioides (1%) | 24.31 ± 0.01 | 39.31 ± 0.43 | [79] | |||
| grape seed (1%) | 21.06 ± 0.27 | 34.48 ± 0.06 | |||||
| Gelatin | Ziziphora clinopodioides (1%) | 24.12 ± 0.18 | 30.80 ± 0.03 | [79] | |||
| grape seed (1%) | 20.54 ± 0.24 | 27.12 ± 0.08 | |||||
| Hydroxypropyl methylcellulose (HPMC) | Oregano (0.75%) | 10.83 ± 0.55 | 2.53 ± 0.07 | 25.46 ± 0.06 | 40 ± 0.34 | 8.65 ± 0.34 | [80] |
| Alginate–apple puree | Oregano (0.1%) | 5.25 ± 0.33 | 2.47 ± 0.37 | 5.75 ± 0.96 | 56.96 ± 3.86 | [81] | |
| Cinnamon (0.5%) | 4.90 ± 0.27 | 2.84 ± 0.48 | 6.86 ± 1.16 | 57.88 ± 5.37 | |||
| Lemongrass (0.5%) | 4.91 ± 0.40 | 2.56 ± 0.46 | 6.02 ± 1.07 | 55.95 ± 5.55 | |||
| Polyvinyl alcohol nanofibre | Cinnamon nanophytosome (5%) | 29 ± 2.01 | 1.07 ± 0.04 | 45.32 ± 5.06 | 36.79 ± 4.8 | 11.07 ± 5.1 | [82] |
| Carboxymethyl cellulose | Zataria multiflora Boiss (3%) | 15.64 ± 0.84 | 5.79 ± 0.29 | 16.96± 0.95 | 20.77 ± 0.51 | [83] |
| Essential Oil | Properties | Food Product | Film Material | References |
|---|---|---|---|---|
| Rosemary | Antimicrobial | Chicken | Cellulose acetate | [111] |
| Cinnamon clove | Antimicrobial | Bakery | Cassava starch | [7] |
| Lemon, thyme and cinnamon | Antibacterial | NA | Chitosan | [112] |
| Cinnamon, winter savory and oregano | Antimicrobial | Bologna and ham | Alginate | [113] |
| Bergamot | Antifungal and antibacterial | NA | Chitosan | [114] |
| Garlic, rosemary, oregano | Antimicrobial | NA | Whey protein isolate (WPI) | [115] |
| Oregano | Antimicrobial (against S. aureus, Shewanella putrefaciens and Yersinia enterocolitica) and antioxidants | NA | Quince seed mucilage | [116] |
| Oregano | Antimicrobial | Pizza | Cellulosic resin | [117] |
| Oregano | Antimicrobial | Ripened sheep cheese model | Polypropylene (PP) and polyethylene terephthalate (PET) | [118] |
| Oregano and thyme | Antimicrobial (against Pseudomonas spp. and coliform bacteria) | Fresh ground beef | Soy protein | [119] |
| Oregano | Antimicrobial | Fresh beef | Whey protein isolate (WPI) | [120] |
| Mixture of oregano, pimento berry, and lemongrass (mixture A) Mixture of nutmeg, lemongrass and citral (mixture B) | Antimicrobial (against L. monocytogenes) | Fresh broccoli | Methylcellulose (MC) and blend of polycaprolactone/alginate (PCL/ALG) | [121] |
| Ginger, turmeric and plai | Antioxidant | NA | Fish skin gelatin | [122] |
| Satureja hortensis | Antibacterial and antioxidant | NA | k-Carrageenan | [123] |
| Oregano and pimento | Antioxidant | Whole beef muscle | Milk protein | [124] |
| Clove | Antibacterial | Fish | Gelatin chitosan | [125] |
| Clove (57) | Antibacterial and antioxidant | Sardine patties | Sunflower protein concentrate | [126] |
| Linalool or methyl chavicol (39) | Antimicrobial | Cheddar cheese | Low-density polyethylene (LDPE) | [126] |
| Oregano and bergamot (58) | Antimicrobial | Formosa plum | Hydroxypropyl methylcellulose and limonene constituent EO Tomatoes | [127] |
| Cinnamon and mustard | Antibacterial | Tomatoes | Zein | [128] |
| Limonene constituent EO, lemongrass and oregano | Antimicrobial | Strawberries | Chitosan | [129] |
| Peppermint, red thyme, chitosan and lemon | Flavoring | Strawberry | Chitosan | [130] |
Publisher’s Note: MDPI stays neutral with regard to jurisdictional claims in published maps and institutional affiliations. |
© 2020 by the authors. Licensee MDPI, Basel, Switzerland. This article is an open access article distributed under the terms and conditions of the Creative Commons Attribution (CC BY) license (http://creativecommons.org/licenses/by/4.0/).
Share and Cite
Syafiq, R.; Sapuan, S.M.; Zuhri, M.Y.M.; Ilyas, R.A.; Nazrin, A.; Sherwani, S.F.K.; Khalina, A. Antimicrobial Activities of Starch-Based Biopolymers and Biocomposites Incorporated with Plant Essential Oils: A Review. Polymers 2020, 12, 2403. https://doi.org/10.3390/polym12102403
Syafiq R, Sapuan SM, Zuhri MYM, Ilyas RA, Nazrin A, Sherwani SFK, Khalina A. Antimicrobial Activities of Starch-Based Biopolymers and Biocomposites Incorporated with Plant Essential Oils: A Review. Polymers. 2020; 12(10):2403. https://doi.org/10.3390/polym12102403
Chicago/Turabian StyleSyafiq, R., S. M. Sapuan, M. Y. M. Zuhri, R. A. Ilyas, A. Nazrin, S. F. K. Sherwani, and A. Khalina. 2020. "Antimicrobial Activities of Starch-Based Biopolymers and Biocomposites Incorporated with Plant Essential Oils: A Review" Polymers 12, no. 10: 2403. https://doi.org/10.3390/polym12102403
APA StyleSyafiq, R., Sapuan, S. M., Zuhri, M. Y. M., Ilyas, R. A., Nazrin, A., Sherwani, S. F. K., & Khalina, A. (2020). Antimicrobial Activities of Starch-Based Biopolymers and Biocomposites Incorporated with Plant Essential Oils: A Review. Polymers, 12(10), 2403. https://doi.org/10.3390/polym12102403

